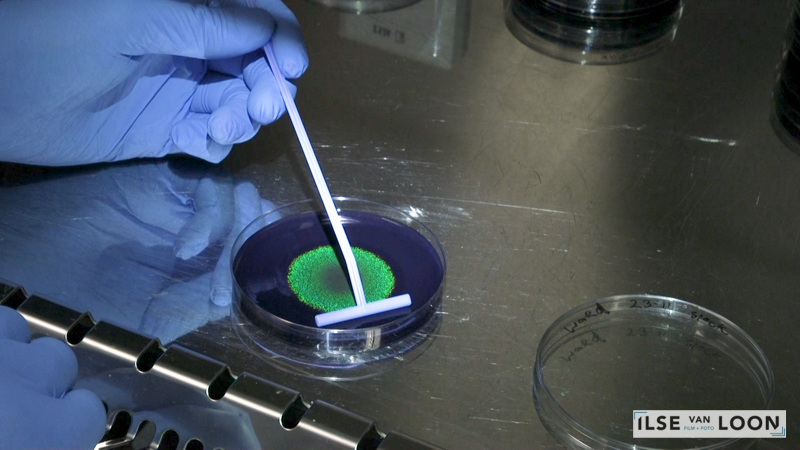

De Material Incubator (MI)
De Material Incubator (MI) is a creative research lab that explores the potentials of materials from living organisms for an alternative notion on the everyday.This movie was made for caradt: Material Incubator, Designing with living Organisms.
Biobased Art and Design
The research group Biobased Art and Design capitalises on the role of artistic practice in unlocking the unique potentials of living organisms, such as algae, fungi, plants and bacteria, for everyday materials and communicating these to a broader public. In doing so, the group aims to instigate and accelerate our widespread understanding, further development and usage of such biological materials. The researchers examine material qualities, addressing their roles and influences. Such qualities are deeply rooted in an organisms character and behaviour, and shape our experiences of materials made with living organisms. Researchers adopt diverse technical and creative methods taking artists, designers and scientists as equal and active partners in the material creation
© 2021 Avans Centre of Applied Research for Art, Design and Technology (Caradt)
Opdrachtgever: Caradt – Avans Hogeschool
Regie | Camera | Montage: Ilse van Loon